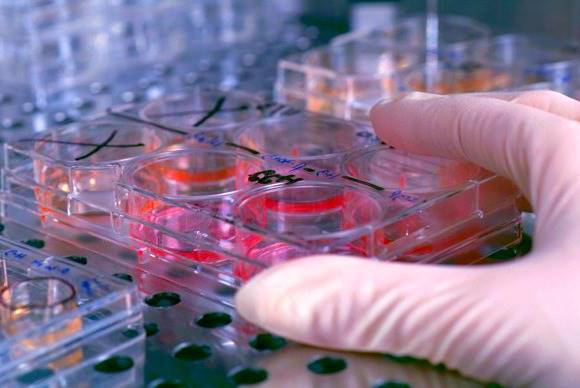

STAMINALI CONTRO IL PARKINSON, DALL’ANNO PROSSIMO I TEST SULL’UOMO
E’ più vicina una nuova terapia anti Parkinson a base di neuroni ottenuti da cellule staminali riprogrammate, le cosiddette staminali pluripotenti indotte (iPs) che hanno fruttato il Nobel della Medicina nel 2012 al giapponese Shinya Yamanaka e all’inglese John Gurdon. Scimmie con sintomi della malattia neurodegenerativa mostrano “significativi benefici” a più di 2 anni dal trapianto con iPs umane, aprendo all’impiego del trattamento sui pazienti.
I risultati dello studio sono pubblicati su ‘Nature‘ dagli scienziati del Center for iPs Cell Research and Application (Cira) della Kyoto University nipponica, che intendono avviare i primi test sull’uomo prima della fine del 2018. Uno degli ultimi step che precedono la sperimentazione clinica di una nuova terapia cellulare cerebrale prevede infatti una ricerca sui primati, per verificarne la sicurezza e la possibile efficacia. Passaggio superato ora con successo.
Le cellule bersaglio del Parkinson, ricordano gli autori, sono i neuroni che producono il neurotrasmettitore dopamina. Da numerosi studi precedenti è emerso che il trapianto di neuroni dopaminergici (Da) ricavati da cellule fetali riesce ad alleviare i sintomi della patologia. Tuttavia l’impiego di tessuto fetale è controverso, mentre le iPs possono essere ottenute dal sangue o della pelle: cellule adulte ‘ringiovanite’ allo stadio di ‘bambine’, riprogrammate in modo da tornare a una condizione di pluripotenza, cioè capaci di dare origine a qualunque cellula dell’organismo. “I nostri dati suggeriscono che i neuroni Da ricavati da cellule iPs funzionano altrettanto bene quanto quelli ottenuti dal tessuto cerebrale fetale”, afferma il neurochirurgo Jun Takahashi, a capo del laboratorio giapponese.
“Abbiamo ottenuto neuroni dopaminergici da diverse linee cellulari iPs – spiega Tetsuhiro Kikuchi, neurochirurgo del gruppo di Takahashi – Alcuni li abbiamo ricavati da cellule iPs da donatori sani, altri da iPs di malati di Parkinson. Ogni animale ha ricevuto neuroni preparati partendo da donatori differenti, il che ci ha permesso di osservare che la qualità delle cellule di diversa provenienza ha una grande influenza sulla sopravvivenza dei neuroni Da” trapiantati. Mentre finora si riteneva che il successo di una terapia cellulare dipendesse dal numero di cellule trasferite in grado di sopravvivere, i nuovi risultati indicano invece che la qualità delle cellule di partenza conta più della quantità di neuroni che resistono nell’organismo ospite.
I ricercatori hanno dunque esaminato il profilo genetico delle cellule dei donatori utilizzati, identificando 11 geni che potevano rappresentare una ‘spia’ di qualità. Fra questi ce n’è uno, chiamato Dlk1, che si era già dimostrato predittivo nei trapianti effettuati sui topi con neuroni Da ottenuti da staminali embrionali. Su questo gene gli studiosi vogliono quindi puntare per ottimizzare la produzione di cellule adatte al trattamento.
Un altro obiettivo dello studio era confrontare i vari metodi disponibili per valutare la sopravvivenza dei neuroni trapiantanti. In questo senso il lavoro promuove la Risonanza magnetica per immagini (Mri) e la Tomografia a emissione di positroni (Pet): “Tecniche non invasive che potranno essere usate sui pazienti” nei futuri trial clinici, dice Takahashi.
In un’altra ricerca sulle scimmie pubblicata su ‘Nature Communications’, la stessa équipe ha scoperto che, perché una terapia cellulare abbia più speranze di successo, donatore e ricevente devono avere un corrispondente profilo immunitario Hla (sistema dell’antigene leucocitario umano, Mhc nei primati). In questo modo, anche se non è possibile evitare una terapia immunosoppressiva per scongiurare il pericolo di rigetto, il trattamento può essere somministrato a dosi inferiori con un minor rischio di infezioni.